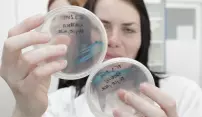
Olomouc ovládne veletrh vědy Olomouc ovládne veletrh vědy

Olomouc ovládne veletrh vědy
Městské parky i prostory univerzity ovládne na dva dny veletrh vědy a výzkumu. Veřejnosti nabídne pohled na vědu, jak ji nezná. Největší populárně-vědeckou akci v regionu podporuje statutární město Olomouc. Akce se koná v pátek 21. a v sobotu 22. června, vstup je zdarma.
Děti i dospělí budou mít ojedinělou možnost poznat prostřednictvím zábavných interaktivních experimentů, exponátů i soutěží různé pohledy na každodenní využití vědy. Těšit se tak mohou na chemické pokusy pro nejmenší, fyziku v kuchyni, roboty, rýžování zlata, matematickou kavárnu nebo laserovou laboratoř. Humanitní obory pak zastoupí například Konfuciova akademie, výroba netradičních hudebních nástrojů nebo experimentální malba.
„Důležité je představit se jako instituce, která dokáže komunikovat se svým okolím a není uzavřena jen pro studium nebo pro vědce, které může vnímat veřejnost jako podivíny,“ říká hlavní řešitel projektu Roman Kubínek. Organizátoři plánují, že by se letos na veletrhu mělo objevit na šest desítek různých prezentačních stánků, a to nejen těch univerzitních, ale i ze středních škol z regionu. V duchu hesla projektu Neděláme z vědy vědu pak bude velká část stanovišť soustředěna do veřejných prostor – parků a přilehlých ulic.
Program a více informací: www.popup.upol.cz
| Poslední úprava: 21. června 2013 (pá)